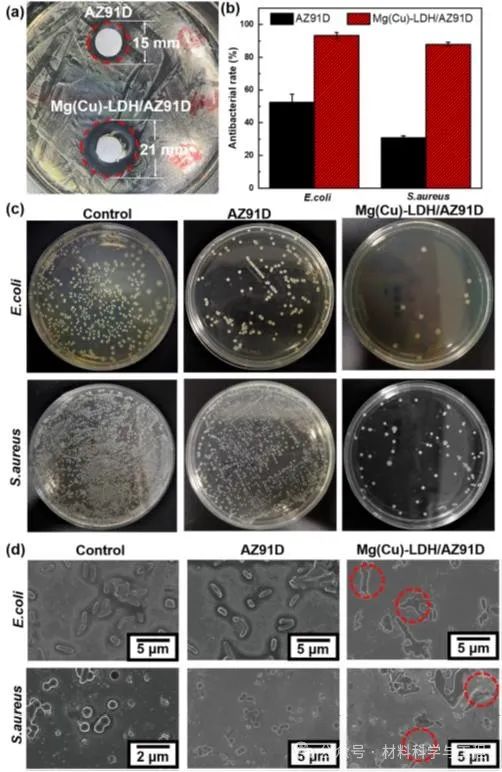

镁合金的密度和弹性模量与人骨接近,具有作为骨科植入物的潜力。然而,镁合金极易发生腐蚀,伴随着植入后细菌感染,常常导致种植失败。因此有必要开发一种具有优异耐蚀性,同时兼具抗菌和促骨再生的新型材料。层状双氢氧化物(LDH)是指两种或两种以上金属元素氢氧化物嵌层组装水滑石层状结构,因其优越的离子交换功能可改善耐蚀性而备受关注。
近日,中南大学等单位的研究者设计了一种具有LDH结构的镁合金涂层,通过共沉淀和水热处理两步法在镁合金表面构建含铜离子的MgAl-LDH,大幅提高耐蚀、抗菌和促成骨的效果。其中短期和长期耐蚀性的提高归因于LDH屏障的作用。镁离子和铜离子双重离子协同抗菌对大肠杆菌和金黄色葡萄球菌有良好的抑制作用。在植入大鼠股骨2周和4周后,组织染色切片表明该材料无毒性且具有良好的成骨作用。相关论文以题为“Enhanced corrosion resistance, antibacterial properties and osteogenesis by Cu ion optimized MgAl-layered double hydroxide on Mg alloy”发表在镁合金顶刊《Journal of Magnesium and Alloys》上。中南大学王清鸽博士为论文第一作者,中南大学吴宏教授和中南大学湘雅二医院刘波副主任医师为论文共同通讯作者。
论文链接: https://doi.org/10.1016/j.jma.2023.08.010
图1 Mg(Cu)-LDH/AZ91D制备过程示意图
图2 (a-b)Mg(Cu)-LDH/AZ91D的SEM形貌图;(c)截面SEM图和(d)Mg(Cu)-LDH/AZ91的EPMA图;(e)AZ91D和Mg(Cu)-LDH/AZ91D的XRD图
图3 (a) 在PBS溶液中浸泡1、3、5、7 和14天后的氢气释放量;(b) 质量损失率;(c) 腐蚀速率;(d) pH值;(e) Mg2+和 Cu2+的离子释放浓度
图4 (a)样品与金黄色葡萄球菌共培养12h的抑菌圈;(b) 样品对大肠杆菌和金黄色葡萄球菌的抑制率,(c) 样品的大肠杆菌和金黄色葡萄球菌涂板照片(d) 样品表面的大肠杆菌和金黄色葡萄球菌的SEM形貌图
图5 植入大鼠股骨2周和4周后的H&E和Masson染色图
吴宏,工学博士,中南大学教授,博士生导师,英国兰卡斯特大学荣誉研究员,入选湖南省“杰出青年”科学基金,湖南省“湖湘青年科技创新创业人才”计划。兼任高分子复杂结构增材制造国家工程研究中心技术委员会副主任,湖南省生物材料学会副会长、理事,湖南省有色金属学会理事、监事等职务。主要从事増材制造(3D打印)与生物医用材料等领域研究工作。主持承担国家自然科学基金、国防科技173计划技术领域基金、国防技术基础科研计划、国家重点研发计划项目子课题、国家863计划项目子课题、教育部博士点科研基金、湖南省重点研发计划等30余项科研项目。发表学术论文100余篇,授权国家发明专利16项。生物医用材料相关工作已发表在Bioactive materials, Acta Biomaterialia, Journal of Magnesium and Alloys, Biomaterials research,Journal of Materials Science & Technology, Biomaterials Science等国际知名期刊上。
刘波,外科学博士,中南大学湘雅二医院副主任医师,硕士生导师,材料科学与工程专业博士后。兼任中国抗癌协会大肠癌专业委员会委员,中国健康管理协会健康科普专业委员会委员,湖南省抗癌协会胃癌专业委员会委员,湘雅消化系微创外科医师联盟理事,广东省科技专家库专家,长沙市科技项目评审专家库专家。主要研究方向为胃肠肿瘤综合治疗与医用材料临床应用。承担国家自然科学基金、国家重点研发计划项目、湖南省自然科学基金等10余项科研项目,发表SCI论文20余篇,授权专利10余项。
免责声明:本网站所转载的文字、图片与视频资料版权归原创作者所有,如果涉及侵权,请第一时间联系本网删除。
官方微信
《腐蚀与防护网电子期刊》征订启事
- 投稿联系:编辑部
- 电话:010-62316606
- 邮箱:fsfhzy666@163.com
- 腐蚀与防护网官方QQ群:140808414